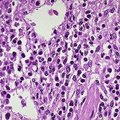
慢性炎症性脫髓鞘性多發性神經根神經病

定義
病因
由於CIDP的臨床表現與AIDP(GBS)在一定程度上的相似性,而且對於糖皮質激素、靜脈注射丙種球蛋白以及血漿交換等免疫調節治療手段有效,推測其發病機制中免疫介導因素占極重要的位置。但是,CIDP發病的始動因素或重要誘發因素尚不清楚。這一點與AIDP顯著不同。AIDP目前公認與感染性前驅疾病有關,最常見的是上呼吸道感染疾病(病毒性或細菌性)和胃腸道炎性疾病(細菌性)。而CIDP的病因學研究並未提示前驅感染與CIDP的關係,CIDP患者相關病毒細菌的檢出率也很低。當然這也可能由於CIDP起病隱匿,不好確定前驅感染與症狀出現的時間有關;或者由於CIDP的發病率比AIDP低很多,且診斷困難,相對較少的流行病學資料尚不足證實前驅疾病與CIDP的關係。
預防
由於CIDP的直接病因以及始動的誘發因素並不明確,所以缺乏明確的一級預防建議。CIDP雖然

治療目標
CIDP是會造成神經功能缺損的自身免疫性周圍神經疾病。大多數患者對於免疫調節治療均有不同程度的效果。在明確CIDP的診斷後,治療目的是減少神經功能缺失和防止疾病的進展和復發。早期診斷並開始針對發病機制的免疫治療能夠減少不可逆的神經功能缺損和生活依賴。
